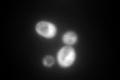
YOL139C
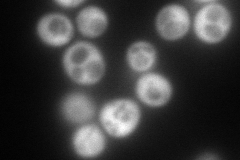
YOL139C
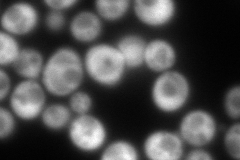
YOL139C
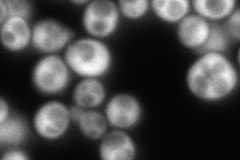
YOL139C
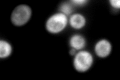
YOL139C

View description
Cytoplasmic mRNA cap binding protein and translation initiation factor eIF4E; the eIF4E-cap complex is responsible for mediating cap-dependent mRNA translation via interactions with translation initiation factor eIF4G (Tif4631p or Tif4632p)
Localization:
Intensity:
Fold change:
Significance:
-
C’ GFP library in SD
cytosol403.25 -
N' NOP1pr-GFP in SD
cytosol274.642 -
N' TEF2pr-mCherry in SD
cytosol277.231 -
N' NATIVEpr-GFP in SD
cytosol291.417 -
N' TEF2pr-VC and Cyto-VN in SD

#N/A0 -
C’ GFP library in SD+DTT
cytosol484.891.2No -
C’ GFP library in SD+H2O2

cytosol303.420.75No -
C’ GFP library in Starvation Media

cytosol390.130.96No -
C’ GFP library on the background of Pup2-DaMP

cytosol -
C’ GFP library on the background of CCT mutant

cytosol381.0350.944904No
